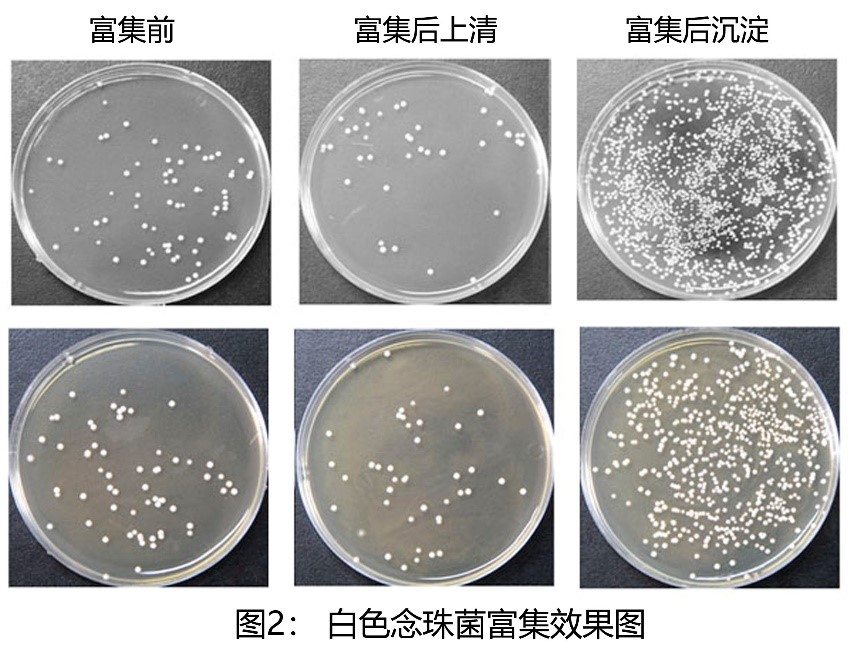

项目简介
本课题发明一种针对临床液相标本中的微生物进行快速浓缩富集的方法和试剂,可以明显地提高临床标本中微生物检测的阳性率。
本方法首先通过磁珠吸附的方式,将临床液体样本(尿液、胸腹水、脑脊液、肺泡灌洗液等)中细菌、真菌或病毒特异性结合于磁珠上,无需高速离心,从而实现病原体的富集;再通过对细菌进行培养、染色、分子生物学或质谱检测,或者对病毒进行免疫荧光或分子生物检测,最终对细菌、真菌或病毒进行鉴定。对临床标本中的细菌、真菌或病毒进行富集,提高了后续鉴定时病原体的初始量,从而极大地提高了鉴定的阳性率。
本产品可以迅速将5~50ml液相样本中微生物浓缩至50~200µl样本中,在磁性环境下可以轻松实现临床标本中细菌、真菌或病毒的浓缩,无需离心,减少了由于离心产生的气溶胶所带来的潜在生物安全隐患。本方法操作简单、无需复杂仪器、耗时短、在源头显著提升临床液相样本中病原微生物检测的灵敏性。

项目团队
沈弢博士现任北京大学基础医学院病原生物学系副教授,博士研究生导师。长期从事分子诊断学和感染免疫学研究。中国疾病预防控制中心性病艾滋病预防控制中心博士毕业,2006~2009年曾在美国克利夫兰临床基金会医院(the Cleveland Clinic)和凯斯西储大学医学院(Case Western Reserve University School ofMedicine)从事博士后研究。北京微生物学会第十一届理事会理事。长期担任《中华微生物学和免疫学杂志》、《中国输血杂志》等杂志编委、参编多部《医学微生物学》相关研究生和本科教材,发表中英文论文60余篇,承担和参与包括国家自然基金、国家科技重大专项等多项研究课题。
应用范围
本产品用于临床液相标本(如尿液、胸腹水、脑脊液、肺泡灌洗液等)中微生物(细菌、真菌或病毒)的浓缩和富集。
项目阶段
产品已完成开发。
知识产权
已经获得相关专利授权。
合作方式
技术转让。
联系方式
邮箱:qxy@bjmu.edu.cn